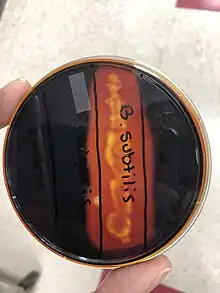

Iodine–starch test
The iodine–starch test is a chemical reaction that is used to test for the presence of starch or for iodine. The combination of starch and iodine is intensely blue-black.[1][2]
The interaction between starch and the triiodide anion (I−
3) is the basis for iodometry.
![]() Schematic view of I3− ions embedded in amylose helix | |
| Classification | Colorimetric method |
|---|---|
| Analytes | Starch |


History and principles
The iodine–starch test was first described in 1814 by Jean-Jacques Colin and Henri-François Gaultier de Claubry,[3] and independently by Friedrich Stromeyer the same year.[4][5]
The triiodide anion instantly produces an intense blue-black colour upon contact with starch. The intensity of the colour decreases with increasing temperature and with the presence of water-miscible organic solvents such as ethanol. The test cannot be performed at very low pH due to the hydrolysis of the starch under these conditions.[6] It is thought that the iodine–iodide mixture combines with the starch to form an infinite polyiodide homopolymer. This was rationalized through single crystal X-ray crystallography and comparative Raman spectroscopy.[7]
Starch as an indicator
Starch is often used in chemistry as an indicator for redox titrations where triiodide is present.[1] Starch forms a very dark blue-black complex with triiodide. However, the complex is not formed if only iodine or only iodide (I−) is present. The colour of the starch complex is so deep, that it can be detected visually when the concentration of the iodine is as low as 20 μM at 20 °C.[8] During iodine titrations, concentrated iodine solutions must be reacted with some titrant, often thiosulfate, in order to remove most of the iodine before the starch is added. This is due to the insolubility of the starch–triiodide complex which may prevent some of the iodine reacting with the titrant. Close to the endpoint, the starch is added, and the titration process is resumed taking into account the amount of thiosulfate added before adding the starch.
The color change can be used to detect moisture or perspiration, as in the Minor test or starch–iodine test.
Starch is also useful in detecting an enzyme called amylase. Many bacteria like Bacillus subtilis can produce such an enzyme to help scientists identify unknown bacterial samples -- the starch-iodine test is one of many tests needed to identify the exact bacterium.[9] The positive test for bacteria that has starch hydrolysis capabilities (able to produce amylase) is the presence of a yellow zone around a colony when iodine is added to detect starch.[10]
Medical Use
Although the starch-iodine test is predominantly employed in the lab, recent assessments have shown potential for clinical use, such as confirming the diagnosis of Horner's syndrome. Hospitals with limited technical accessibility can exploit this diagnostic tool since it requires resources that may be easily attainable. In order to perform the experiment, a patient's skin is first dried with 70% alcohol; with the iodine solution added, subsequently. After the skin dries completely once more, it will be dusted with a starch material. Inducing sweating conditions will cause the skin to turn dark blue. Physicians can then make a diagnosis if the test shows sweating of different intensities on the left and right side of the body.[11]
See also
- Lugol's iodine
- Counterfeit banknote detection pen
References
- Cochran, Beverly; Lunday, Deborah; Miskevich, Frank (2008). "Kinetic Analysis of Amylase Using Quantitative Benedict's and Iodine Starch Reagents". Journal of Chemical Education. 85 (3): 401. Bibcode:2008JChEd..85..401C. doi:10.1021/ed085p401.
- Naiman, Barnet (1937). "Preservation of starch indicator". Journal of Chemical Education. 14 (3): 138. Bibcode:1937JChEd..14..138N. doi:10.1021/ed014p138.1.
- Colin, J. J.; Gaultier de Clauby, H. F. (1814). "Mémoire sur les Combinaisons de l'Iode avec les Substances Végétales et Animales". Annales de Chimie. 90: 87–100.
- Stromeyer, F. (1815). "Ein sehr empfindliches Reagens für Jodine, aufgefunden in der Stärke (Amidon)" [A very sensitive reagent for iodines, found in starch (amidone)]. Annalen der Physik. 49 (1–2): 146–153. Bibcode:1815AnP....49..146S. doi:10.1002/andp.18150490108.
- Greenwood, Norman N.; Earnshaw, Alan (1997). Chemistry of the Elements (2nd ed.). Butterworth-Heinemann. ISBN 978-0-08-037941-8.
- "Iodine Test for Starch". Brilliant Biology Student Master Biology Labs. Retrieved 2015-12-01.
- Madhu, Sheri; Evans, Hayden A.; Doan-Nguyen, Vicky V. T.; Labram, John G.; Wu, Guang; Chabinyc, Michael L.; Seshadri, Ram; Wudl, Fred (4 July 2016). "Infinite Polyiodide Chains in the Pyrroloperylene-Iodine Complex: Insights into the Starch–Iodine and Perylene–Iodine Complexes". Angewandte Chemie International Edition. 55 (28): 8032–8035. doi:10.1002/anie.201601585. PMID 27239781.
- Bertrand, Gary. "Iodine Clock Reaction". Missouri University of Science and Technology. Retrieved 2019-05-18.
- Tortora, Gerard J.; Funke, Berdell R.; Case, Christine L. (2019). Microbiology: an introduction (Thirteenth ed.). Boston: Pearson. ISBN 0134605187.
- Hankin, Lester; Anagnostakis, S. L. (1975). "The Use of Solid Media for Detection of Enzyme Production by Fungi". Mycologia. 67 (3): 597–607. doi:10.2307/3758395. ISSN 0027-5514.
- Ribeiro, Luís; Rocha, Raquel; Martins, João; Monteiro, Ana (September 2020). "Starch–iodine test: a diagnostic tool for Horner syndrome". BMJ Case Reports. 13 (9): e238541. doi:10.1136/bcr-2020-238541. ISSN 1757-790X. PMC 7484882.
Further reading
- Vogel's Textbook of Quantitative Chemical Analysis, 5th edition.
External links
- How does starch indicate iodine? General Chemistry Online
- Iodine test at Braukaiser
- Titrations.info: Potentiometric titration--Solutions used in iodometric titrations
